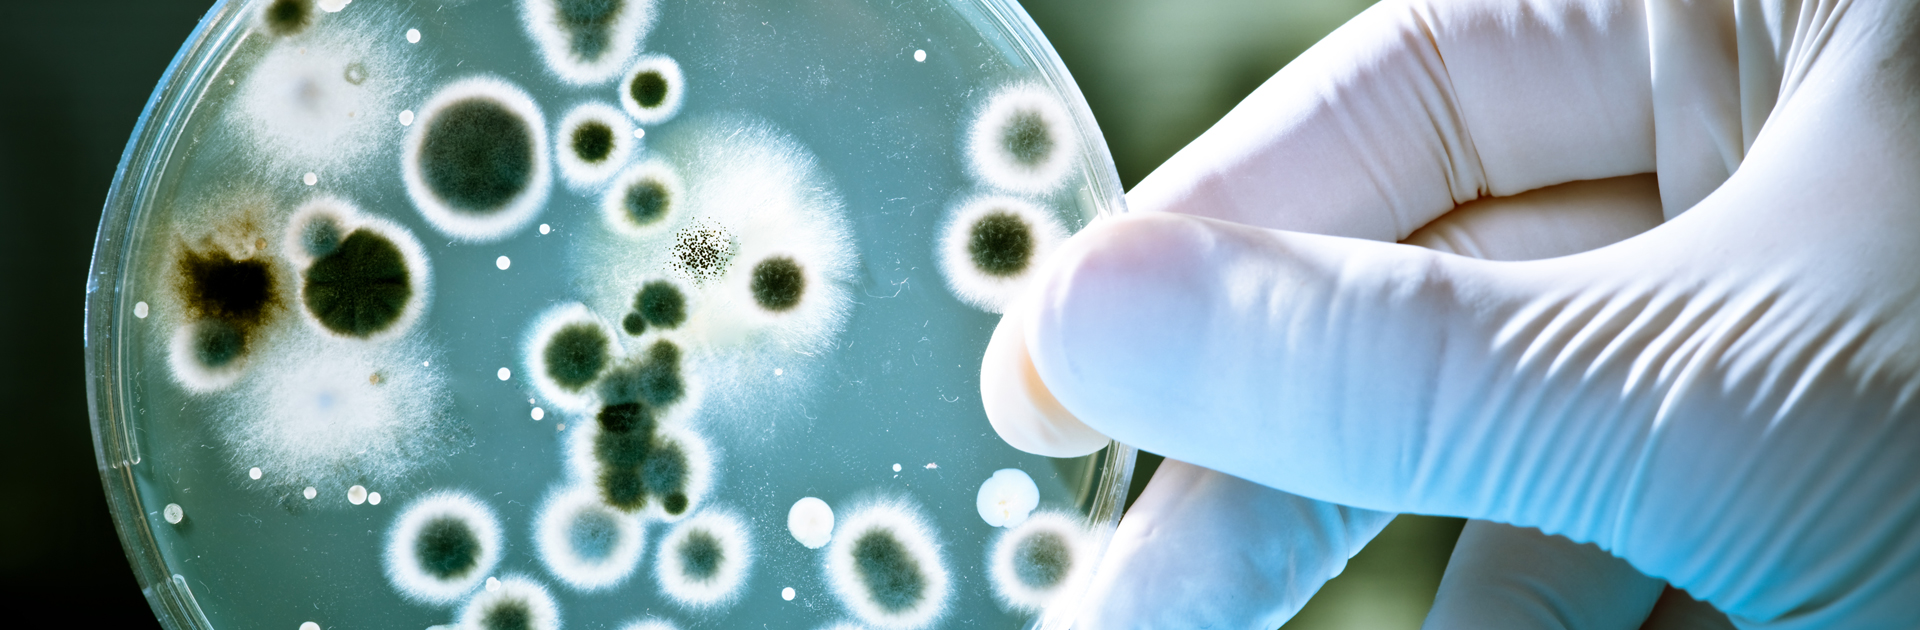

Hastane
Merkezi kanal sistemine (HVAC) sahip olan olmayan hastanelerde Sterilizasyon için kullanılmaktadır. Karantina ve izolasyon odaları, Yoğun Bakım, Yeni Doğan Üniteleri gibi
Daha fazlası

Üretim
Endüstriyel alanda üretim yapan kuruluşların paketli yiyeceklerde kullanılan Alkol, Azot ve etken maddelerin tamamen ortadan kaldırılması
Daha fazlası

Laboratuvarlar
Laboratuvarlarında indoor hava kalitesinin sağlanması, Staphylococcus aureus, Pseudomonas aeruginosa, Legionella pneumophila vs. yok edilmesi
Daha fazlası

Patojenlerin Yayılımı
Bu resimde, virus, bakteri, mantar ve mantar sporlarının nasıl dağıldığını görmekteyiz.
Kullanmakta olduğumuz bioaerosel ürünler (dezenfektanlar); giysi, yüz maskesi ve kıyafetler üzerinden ayrılarak, havada asılı kalarak bulaşma ve yayılım hızını arttırırlar.
Kendimizi korurken, diğer kişilere bulaşma yolunu açmış ve hızlandırmış olmaktayız. Bu gibi vakalarda karantinanın uygulamaları önem arz etmektedir.
Virobuster - Steritube
İklimlendirme Santrallerinde HEPA filtre önemli bir amaca hizmet etmektedir. HEPA filtrelerinde "Yakala-Tut" işlevi bulunmaktadır. Düzenli olarak değiştirilmeleri gerekmektedir. "Yakala-Tut" işlevinin sonucunda; filtrenin hemen arka tarafında Mantar ve Mantar Sporlarının (Fungi and Fungi Spores) üremekte ve hava kanalları ile doğrudan çalışan, hasta üzerine nüfuz etmektedir.
Steritube bu nokta devreye girmektedir.
- Virus, Bakteri, Mantar ve Mantar Sporlarını %99.99 yok eder
- Mutasyon oluşturmaz %100 öldürür
- Hiçbir şekilde Ozon (O3), VOC, mVOC salınımı yapmaz
- Gıda, ilaç ve insan üzerinde sıfır etki özelliği
- Pirojen oluşturmaz ve Yüzeyde zarar verici bozulma yapmaz
Uygulama Alanları
Yoğun Bakım ve Reanimasyon
KVC, Cerrahi, Koroner, Dahiliye ve Yenidoğan yoğun bakım ve reanimasyon indoor hava kalitesi
Yeni Doğan Üniteleri
Yenidoğan ünitelerinde steril ortam
Karantina ve İzolasyon Odaları
Bronkoskopi, Balgam indüksiyon, Acil Servis, Triyaj Alanları, Radyoloji bekleme odaları vs.
Tüberküloz (Verem) Merkezleri
TB merkezlerinde indoor hava standartlarını sağlar
Kemik İliği Transplantasyon
Aspergillus, Adeno, Varicella-zoster, TB, Histoplasma capsultum vs. yok edilerek indoor hava kalitesi
Organ Nakil ve Yanık Üniteleri
S. aureus, Enterococcus spp., Aspergillus spp. vs. indoor hava kalitesi
Poliklinikler
Hasta muayene odaları ve koridorlarda steril hava
Diş Klinikleri
Implant ve diş operasyonlarında hasta tarafından bulaşmaya karşı en etkili çözüm
Çalışma Ofisleri
Açık ofis ve büro ortamlarında indoor hava kalitesi
Bankalar, Oteller, Kütüphaneler
Nüfus popülasyonun bulunduğu bütün ortamlarda indoor hava kalitesi
Paketli Ürün Üretim Tesisleri
Paketli ürünlerin ambalajlarında kullanılan Azot (N2) ve Alkol kullanımın ortadan kaldırılması
Ekmek Üretim Tesisleri
Ekmek israfı ve katkı maddelerinin ortadan kaldırılması, indoor hava kalitesi